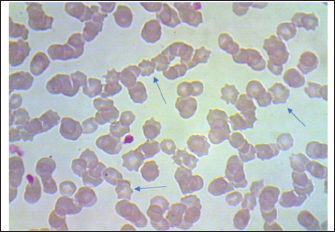

| Research Article | ||
Open Vet. J.. 2026; 16(2): 861-869 Open Veterinary Journal, (2026), Vol. 16(2): 861-869 Research Article Evaluation of multiple methods for the diagnosis of equine Hemomycoplasmosis in Misan, IraqAli Jarad and Kamal M. Alsaad*Department of Internal and Preventive Medicine, College of Veterinary Medicine, University of Basrah, Basrah, Iraq *Corresponding Author: Kamal M. Alsaad. Department of Internal and Preventive Medicine, College of Veterinary Medicine, University of Basrah, Basrah, Iraq. Email: kamalsad58 [at] yahoo.com Submitted: 08/10/2025 Revised: 30/12/2025 Accepted: 16/01/2026 Published: 28/02/2026 © 2026 Open Veterinary Journal
AbstractBackground: Hemomycoplasmosis caused by Hemotropic mycoplasmas, or Hemoplasma, which were previously classified as Eperythrozoon spp., are uncultivable parasites that infect the cell wall of erythrocytes in many susceptible mammals, including cattle, buffalo, goats, sheep, horses, cats, dogs, and even camels, and can be transmitted to humans. Aim: The purpose of the present work is to display and evaluate the different diagnostic criteria for detecting the most precise method for diagnosing Hemomycoplasma in horses. Methods: Different diagnostic methods were used to diagnose equine Hemomycoplasmosis caused by Mycoplasma haemofelis. Including cytological examinations (Giemsa stain blood smears and fluorescent microscopical diagnosis using acridine orange staining) as well as evaluation of the acute phase response reaction, Molecular diagnosis via quantitative polymerase chain reaction (qPCR), and postmortem examination of dead carcasses Results: cytological diagnosis revealed an infection rate of 88% (88/100), while the molecular diagnosis via qPCR confirmed infection in 79% (79/100) of the samples. The agreement between the two diagnostic methods was analyzed using Cohen's Kappa statistic. The observed agreement was 91% (91/100), and the expected agreement by chance was 72.04%. The calculated Kappa coefficient was κ=0.678 [95%, (confidence interval)], indicating substantial agreement between cytological and qPCR diagnoses according to the Landis and Koch benchmark. The findings also showed that infected horses exhibit significant differences in the acute phase response; additionally, dead carcasses displayed general emaciation, paleness of internal organs, obvious splenomegaly, and enlarged liver, kidneys, and heart, which showed white patches. Furthermore, histopathological changes indicate degeneration and necrosis in cardiac muscles, besides atrophic glomeruli, accompanied by the dilatation of renal tubules in the kidneys, as well as a marked reduction in the proportion of white pulp of splenic tissue and degenerative changes in the cytoplasm of hepatocytes, accompanied by nuclear alterations characterized by loss of chromatin content in the hepatic tissue. Conclusion: It was concluded that evaluating different tests for diagnosing equine Hemomycoplasmosis is very important to identify the most accurate one and use it confidently in the future. Additionally, although the diagnostic criteria and accuracy of each test vary, each test has its advantages and disadvantages. Moreover, Cytological diagnosis is still advised for field screening, whereas qPCR is for confirmatory diagnosis. Keywords: Acute phase response, Cytology, Equine diagnosis, Hemoplasma, qPCR. IntroductionHemomycoplasmosis caused by Hemotropic mycoplasmas, or Hemoplasma, which were previously classified as Eperythrozoon spp., are uncultivable parasites that infect the cell wall of erythrocytes in many susceptible mammals, including cattle, buffalo, camels, goats, sheep, horses, cats, dogs, and can be transmitted to humans (Saki, 2009; Constable et al., 2017). However, latent and mild infections can also be observed in deer, elk, and mules, where Hemoplasma spp. is species-specific (Messick, 2004; Tasker, 2020). The organism known to cause Hemotropic mycoplasmosis in all domestic and some wild animals leads to significant clinical disease, mainly characterized by hemolytic anemia, poor performance, and emaciation, as well as reduced productivity in livestock, ultimately resulting in death. The disease is found worldwide in various regions(Neimark et al., 2001). Nevertheless, it has been reported in different parts of Iraq (Jarad and Alsaad, 2016; Abed and Alsaad, 2017; Esmaeel and Albadranim, 2019). In horses, Hemomycoplasmosis is mainly caused by Hemomycoplasma haemofelis (Mycoplasma haemofelis). The organisms classified within the genus Mycoplasma are identified based on the 16S rRNA gene and RNase P RNA gene. According to Messick (2004) and Constable et al. (2017), a pleomorphic organism, which often appears as coccoid, rod, and ring shapes, invades the outer surface of red blood cells and is transmitted mechanically by arthropod parasites (Saki, 2009). In horses, the organism was identified in 1978 during a large and noticeable epidemic in Nigerian horses, and it was confirmed by molecular diagnosis in 2010, causing substantial economic losses (Dieckmann et al., 2012; Kinoshita etal., 2024; Ballados-González et al., 2025). Several diagnostic methods are used to identify the causative agent in suspected infected animals, including Giemsa or Romanowsky stains. Cytologic diagnosis of Hemotropic mycoplasma involves examining stained blood smears for bacteria on the surface of red blood cells (Stockham and Scottet, 2025). While this method can indicate infection, it is known to have low sensitivity and specificity, which could be due to cross-reactions, meaning it may miss infections or misdiagnose other conditions (Woronzoff-Dashkoff, 2002). Blood smears are examined for the visual presence of the causative organism. It should be noted that an experienced examiner can often distinguish between bacteria parasitizing the cell walls of red blood cells and other elements, such as Rickettsia, Anaplasma marginale, and the Howell–Jolly bodies (Stockham and Scottet, 2025). Fluorescence diagnosis of Hemotropic mycoplasma involves using fluorescent dyes to detect these microorganisms in red blood cells. Specifically, fluorescent dyes like Hoechst (this dye stains DNA and is commonly used to detect mycoplasma contamination in cell cultures, according to a resource) or DRAQ5 (this dye specifically targets nucleic acids and is used for detecting hemoplasmas in red blood cells) are utilized for visualization and quantification. Samples are observed under a fluorescence microscope to visualize the fluorescently labeled bacteria (Ciancaglini et al., 2005; Ligasová et al., 2019). Enzyme-Linked Immunosorbent Assay (ELISA) is a biochemical technique used to detect the presence of antibodies or antigens in a sample. It involves using antibodies that bind to a specific antigen, then employing a detection system to measure the reaction. It can be used to diagnose Hemotropic mycoplasma infections, but it is not always the most reliable method. While ELISA helps screen rodent colonies for Mycoplasma pulmonis, it has limitations such as cross-reactivity with other mycoplasmas and variability in results (Atharv et al., 2023). ELISA can be prone to cross-reactivity with other similar Mycoplasma species, leading to false-positive results. Additionally, in some cases, animals may not produce detectable antibodies early in the infection, which can result in false-negative outcomes, especially when the infection is at low levels. ELISA might not be sensitive enough to detect minimal levels of infection or in chronic infections where parasitemia is low (Novacco, 2012). The body's initial response to immunological stress is the innate, nonspecific reaction that occurs before specific immune responses develop. The acute phase response (APR) is a key systemic reaction to local or overall disturbances in homeostasis caused by infection, trauma, tissue damage, surgery, tumor growth, or various immunological disorders (Vilhena et al., 2018; Mouliou, 2023). At the site of microorganism invasion and tissue injury, several tissue responses are triggered. Proinflammatory cytokines are released, and the vascular system, along with inflammatory cells, is activated. These responses, in turn, lead to the production of additional cytokines and other inflammatory mediators, which are released into the extracellular fluid and circulate through the bloodstream (Jain et al., 2011). The APR is part of the innate immune response, characterized by changes in serum acute phase protein (APP) concentrations, which can serve as diagnostic and therapeutic biomarkers (Vilhena et al., 2018). Measuring APPs is widely used in human medicine, and there is growing interest in their application in companion animals (Cary et al., 2009), although limited studies have been conducted in horses (Stockham and Scott, 2025). To the best of the authors’ knowledge, the only study assessing the APR to Hemomycoplasmosis in cats reported elevated haptoglobin levels in six animals experimentally infected with Mycoplasma haemofelis (Tasker et al., 2018). The polymerase chain reaction (PCR) shows higher sensitivity and specificity than serological and cytological tests for detecting Hemotropic mycoplasma infections (Beus et al., 2024). PCR is a molecular diagnostic technique that amplifies specific DNA sequences of the mycoplasma, providing high sensitivity and specificity. PCR can also identify the exact species of Hemotropic mycoplasma (Ajaj et al., 2025). It is a highly effective method for diagnosing Hemotropic mycoplasma infections, especially when microscopic examination of blood smears is inconclusive or challenging. PCR assays enable rapid and accurate detection and identification of various hemoplasma species, such as M. haemofelis (Tasker et al., 2018). The real-time PCR assay described offers a reliable method for diagnosing infection and quantifying equine hemoplasma DNA in blood samples. It provides advantages such as faster processing, higher throughput, and a lower risk of false-positive results compared to conventional PCR. It is hoped that quantification will help veterinarians determine the significance of a positive PCR result, which can be problematic with infections like M. haemofelis, as these always cause disease in the host. The assay could also be used to monitor response to treatment. The differing pathogenicity of these species has been previously reported (Ajaj et al., 2025). Post-mortem diagnosis of Hemotropic mycoplasma infections involves examining tissues, particularly the heart, spleen, kidney, and liver, for macroscopic and microscopic changes. Histopathology, including staining with hematoxylin and eosin, is crucial for identifying characteristic lesions. It has been documented that enlargement of the spleen (splenomegaly), congestion, and a soft consistency are common findings. The white pulp may be prominent. On the other hand, enlargement and a distinctive rust-brown discoloration due to hemossiderin deposition are characteristic. Further, the liver may show moderate periacinar necrosis (Al Matwari et al., 2022). Moreover, De Oliveira Battisti et al. (2024) added that gelatinous epicardial fat on the heart, moderate non-suppurative pneumonia, distended gallbladder (cholecystitis), and evidence of vasculitis (edema and exudates) may also be observed. Several methods are generally available for detecting Mycoplasma. Each has its advantages and disadvantages in terms of speed, specificity, sensitivity, accuracy, and overall cost. No quantified diagnostic agreement study is available for equine hemomycoplasmosis under real working conditions in (Misan, Iraq); therefore, the purpose of the present work is to display and evaluate the different diagnostic criteria for detecting the most precise method of Hemomycoplasma in horses. Materials and MethodsAnimals and the study areaThe current study involved 100 suspected male draft horses (The sample size was calculated assuming 50% expected prevalence of equine hemoplasmosis in the region, with 95% confidence level and 10% margin of error, resulting in a required sample of 100 horses), aged 3–5 years, in Misan, Iraq, housed in scattered enclosures within an indoor feeding system. Twenty-five healthy male draft horses were selected as the control group. All horses underwent complete clinical examinations. Additionally, blood smears and fecal samples were analyzed to exclude blood and gastrointestinal parasitic infections. Mandal (2025). Hematological assessments included EDTA-anticoagulated blood samples used for a complete blood count, performed with the XP-300 Automated Hematology Analyzer (Sysmex America). According to Stockham and Scott (2025), blood ear smears were prepared, air-dried, fixed in methanol, and then stained with Giemsa. Microscopic examination was conducted at 1000x magnification using immersion oil on the Olympus BX50 microscope. Additionally, 0.01% acridine orange, a fluorochrome, was used as described by Ciancaglini et al. (2005) to stain blood smears for examination under a fluorescent microscope, serving as a confirmatory diagnosis of the causative agent. A blood sample was taken from the horse's jugular vein and used to extract serum to assess the acute phase response. This included measuring serum haptoglobin (using the Haptoglobin ELISA method) following the manufacturer's instructions from Biotechnology Co., China, as well as testing serum C-reactive protein and plasma fibrinogen spectrophotometrically, according to the manufacturer’s instructions from Biolabo, France. Molecular diagnosis and real-time PCR (qPCR)Using a Blood Genomic Extraction Kit (Geneaid, Taiwan), the DNA was extracted from 200 µl of blood according to the manufacturer's instructions. We used the Nanodrop device (Thermo Fisher, USA) to determine the amount of DNA in the sample and its purity. Finally, the eluted DNA was stored at −20°C until it was used for PCR. Specific primers and SYBR Green were used for the detection of the 16S RNA gene of Mycoplasma haemofelis based on the Forward primer: CGGCCAAGGTTAGTGGCAAACGG, and the Reverse primer: TCCCTCAGCGCCCGAAGGCT (GenBank Accession Number AF178677.1). Perform real-time PCR using Qiagen HotStarTaq Master Mix (UK) with 200 nM primers, 100 nM SYBR Green (diluted 1:100,000) from Sigma-Aldrich, 4.5 mM MgCl₂, and 5 μl of DNA in a total volume of 25 μl. Combine all reactants into a master mix, then aliquot into 96-well PCR plates (Thermofast, Abgene). Add 5 μl of the DNA sample last. Include a negative control (water) in each run. Run the PCR on an iCycler IQ (QuantStudio 5, Applied Biosystems) with an initial step at 95°C for 10 minutes, followed by 55 cycles of 95°C for 10 seconds and 60°C for 60 seconds, collecting fluorescence data. For SYBR Green, extend the protocol with stepwise heating from 75°C to 95°C in 0.5°C increments, holding 15 seconds at each step to record a melting curve. Post-mortem examinationsPost mortem macroscopic examination of dead carcasses includes an examination of the internal organs (heart, liver, kidney, spleen, whole digestive system, and skeletal muscles. Moreover, Specimens for histopathology were taken from the same organs, and suspected tissues were prepared and stained with the standard hematoxylin and eosin. They were then examined under a light microscope (Bancroft et al., 2018). Statistical analysisDiagnostic agreement between cytology and qPCR was assessed using Cohen's Kappa coefficient (κ) with a 95% confidence interval. Additionally, analysis of statistical significance was performed according to Leech et al. (2015), where the statistical program SPSS version (16) was applied via student t-test (p < 0.05) was set as a significant value. Ethical approvalThe animal ethics committee granted final approval and permission to conduct this scientific research, as stated in the official document stated by the College of Veterinary Medicine. CVM-UB/IEC/93/37/2025, issued by the College of Veterinary Medicine, University of Basrah.Iraq. Dated: 12/2/2025. ResultsClinical signsDiseased horses exhibit signs of increased body temperature, rapid respiration, and a rapid, strong heart rate, as well as signs of anemia, including pale mucous membranes of the nictitating membranes and conjunctivae. Moreover, diseased horses exhibited poor performance, lethargy, loss of body weight, and edematous swelling of the fetlock area. In addition to observing ticks parasitizing different areas of the diseased animal's body. CytologyOn Giemsa stain blood smears, M. haemofelis appears spherical or rod-like in shape, found alone or in chains, invading the erythrocyte cell wall, and detected in 88%(88/100) of diseased horses. However, the parasitic blood cells vary in form, such as anisocytic and/or poikilocytic shapes (Fig. 1). On the other hand, the cytological diagnosis of the causative agent using fluorescent microscopy was also confirmed by employing acridine dye, as the bacterium fluoresces when invading the erythrocyte cell wall in 88%(80/100) of diseased horses (Fig. 2).
Fig. 1. Giemsa stain blood smear indicates equine RBCs infected with Mycoplasma haemofelis. 1000X.
Fig. 2. Blood smear indicates Mycoplasma haemofelis invades equine RBCs. Fluorescent microscopy,0.1% acridine orange staining. 1000X. qPCR resultIn the current study, 79%(79/100) of diseased horses were found to be positive using qPCR (Figs. 3 and 4). The agreement between the two diagnostic methods was analyzed using Cohen's Kappa statistic. The observed agreement was 91% (91/100), and the expected agreement by chance was 72.04%. The calculated Kappa coefficient was κ=0.678 (95% CI), indicating substantial agreement between cytological and qPCR diagnoses according to the Landis and Koch benchmark Table 1.
Fig. 3. Amplification plot of the 16S rRNA gene of Mycoplasma haemofelis positive samples.
Fig. 4. Melt curve plot of the 16S rRNA gene of mycoplasma haemofelis positive samples. Table 1. Diagnostic agreement analysis between cytological examination and qPCR for the detection of equine Hemomycoplasmosis
Acute phase responseResults from the evaluation of the acute phase response in diseased horses in the current study show a significant decrease (p < 0.05) in haptoglobin levels and fibrinogen time in diseased horses compared to controls. In contrast, significant increases in C-reactive protein were observed in horses infected with Hemomycoplasma compared to controls Table 2. Table 2. Acute phase response shift of horses indicates a hemolytic response typical of hemoplasma haemofelis infection and controls.
Post-mortem examination resultsPost-mortem examinations of the dead horses infected with M. haemofelis revealed signs of overall emaciation in the affected animals, paleness of internal organs (Fig. 5), and prominent splenomegaly. The liver, kidneys were enlarged; however, the heart showed white patches. Moreover, histopathological changes were characterized by different histopathological changes of eosinophilic degeneration of cardiac muscle fibers, accompanied by atrophy in some fibers, with bleeding between fibers, besides atrophic glomeruli, accompanied with the dilatation of renal tubules in the kidneys, as well as marked reduction in the proportion of white pulp of splenic tissue and degenerative changes in the cytoplasm of hepatocytes, accompanied by nuclear alterations characterized by loss of chromatin content in the hepatic tissue (Figs. 6–9).
Fig. 5. Paleness of internal organ (Digestive system).
Fig. 6. Histopathological examination of the heart revealed eosinophilic degeneration (arrows) of cardiac muscle fibers, accompanied by atrophy in some fibers (arrowhead), with bleeding between fibers (asterisk), H&E, 40x.scale bar=5µm.
Fig. 7. Histological section of the kidney showing dilatation of renal tubular lumina (asterisk), with karyopyknosis of the lining epithelial cells (arrows), H&E,40x. Scale bar=5µm.
Fig. 8. Histopathological evaluation of the spleen showed a marked reduction in the proportion of white pulp (white asterisk) relative to red pulp (black asterisk), H&E,4x. Scale bar=5µm.
Fig. 9. sections demonstrated degenerative changes in the cytoplasm of hepatocytes (arrows), accompanied by nuclear alterations characterized by loss of chromatin content (arrowhead), H&E, 40x. Scale bar=5µm. DiscussionIn this study, multiple methods were used to diagnose the disease and identify the causative agent in infected horses. Despite the variety of diagnostic approaches and slight differences in their accuracy, they remain among the most reliable options in this context. Generally, it can be said that Giemsa-stained blood smears help diagnose various conditions by enabling microscopic identification of blood cells, microorganisms, and other abnormalities. Key diagnostic uses include the definitive identification of blood parasites through thick and thin blood films. Additionally, they are useful for investigating anemia by examining red blood cell morphology and diagnosing leukocyte abnormalities and other blood cell disorders by detecting abnormal cells and features. Nonetheless, Giemsa-stained blood smears allow the assessment of red blood cell size, color, and other characteristics to help diagnose various types of anemia (Woronzoff-Dashkoff, 2002; Stockham and Scott, 2025). On the other hand, Acridine orange blood smear diagnosis is a quick, fluorescence microscopy-based technique that detects nucleic acids (DNA and RNA) in blood, enabling rapid identification of most blood parasites, blood-borne bacteria, and protozoa. The dye highlights DNA in yellow-green and RNA in bright red, facilitating rapid screening and potential early diagnosis of infections. However, some limitations include the inability to preserve the smears and potential issues with low parasitemia or specific organisms. Additionally, the method is based on enzymatic labeling and modified nucleotides, utilizing nicks in the DNA of mycoplasmas. Modified nucleotides are incorporated into the mycoplasmas' DNA and subsequently visualized through immunofluorescence microscopy. This approach is strain-independent, does not heavily stain nuclear DNA, does not stain other bacteria, and offers higher sensitivity than direct labeling methods using DAPI or Hoechst dyes (Ciancaglini et al., 2005; Ligasová et al., 2019). Hereby, the results indicated a high infection rate, which may confirm that relying on the cytological method in diagnosis may be acceptable from a scientific and practical standpoint. The main benefit of real-time PCR assays is their ability to accurately quantify target nucleic acids. The detection mechanism of a real-time PCR system also enhances the assay's sensitivity (Artikai, 2022; Martineau et al., 2023). Additionally, quantitative real-time PCR has transformed molecular diagnostics with its simplicity, increased sensitivity and specificity, and quick turnaround time. However, quantitative PCR-based assays provide a clear advantage over other serological or conventional diagnostic methods (Ajaj et al., 2025). Over the past few decades, qPCR technology has gradually replaced several culture methods. Instead of relying on cytological or antigen-based data to identify pathogens, qPCR works by deliberately amplifying DNA fragments unique to a pathogen’s genome. The method is both accurate and fast. Unlike culture methods, which can take days to provide results, qPCR tests can be completed within hours. However, potential technical shortcomings that may affect assay performance and lead to false results include inadequate sample storage, problems with the preparation and quality of nucleic acids, poor selection of reverse-transcription primers and probes for PCR, and improper data analysis and statistical methods (Artika et al., 2020). In general, cytology can give false positives and whereas qPCR might miss low DNA samples. The acute phase response is a vital protective physiological reaction to infection, injury, and stress, aimed at restoring homeostasis by containing and destroying pathogens, removing damaged tissue, and promoting repair. In the present study, acute-phase responses were investigated by estimating haptoglobin, fibrinogen, and C-reactive protein levels (Cary et al., 2009; Vilhena et al., 2018). It was documented that in hemolytic anemia, red blood cells are destroyed prematurely, releasing hemoglobin into the bloodstream. Haptoglobin, a protein produced by the liver, binds to this free hemoglobin. When there is extensive red blood cell destruction, haptoglobin levels become depleted, leading to low haptoglobin levels in the blood, which is considered a key indicator of hemolytic anemia (as indicated in the current study). A low haptoglobin level indicates that red blood cells are being destroyed, although it doesn't specify the cause (Jain et al., 2011). Moreover, Korman et al. (2012) found that in Hemomycoplasma infection, there was a trend for decreased haptoglobin concentrations, likely because circulating haptoglobin complexes with hemoglobin, causing transient decreases in haptoglobin during hemolysis. Furthermore, Fibrinogen is a vital part of the acute phase response, acting as a classic acute phase reactant that significantly increases or decreases (through liberation or consumption) during inflammation and injury to form a protective fibrin clot at the injury site. This clot helps contain blood loss, prevents microbial infection, and provides a framework for immune cells and fibroblasts to kick-start tissue repair. Fibrinogen also affects leukocyte function and transmigration, supporting the inflammatory response and helping to resolve tissue damage, Thrall (2012). Conversely, Muszbek et al. (2008) noted that hypofibrinogenemia might indicate early hepatic failure or insufficiency when liver functions decline, while hyperfibrinolysis, decreased fibrinogen synthesis, and increased fibrinogen consumption occur when disseminated intravascular coagulation has been triggered. It has been shown that C-reactive protein (CRP) is a substance produced by the liver in response to inflammation, and it is often used as a marker of inflammation in the body. Generally, significantly increasing its levels could indicate infection and cardiac risk Mouliou (2023). Furthermore, High CRP levels may mean an acute or chronic health condition, such as infections from bacteria or viruses. Additionally, Arfuso et al. (2023) added that abnormal CRP values indicate an increased risk of clotting or bleeding disorders. Thereby, it can be concluded that the evaluation of acute phase response is indeed an aid to the diagnosis of diseases causing anemia and tissue damage, as confirmed in this study. The importance of diagnostic criteria of postmortem diagnosis on both macro- and micro diagnosis of the dead carcasses is crucial in animals for several reasons, including determining the cause of death, identifying disease outbreaks in herds, safeguarding public and animal health by detecting zoonotic diseases, contributing to quality assurance, and providing closure for owners. A thorough postmortem helps veterinarians solve problems on farms, prevent future illnesses, and make informed decisions about animal welfare and herd management (Al Matwari et al., 2022; Martineau et al., 2023; De Oliveira Battisti et al., 2024). In the present study, the results of the autopsy of horses that died as a result of infection with equine Hemomycoplasmosis proved that the animals suffered from clear signs of anemia, in addition to gross and microscopic changes in various parts of the animal’s body, concentrated in the liver, spleen, kidneys and heart, which proves the great pathological effects caused by this disease. This is also noted by others (Dieckmann et al., 2012; Diab et al., 2017; Ballados-González et al., 2025). The evidence from this study supports the recommendation for practical diagnosis that cytological diagnosis is still advised for field screening; on the other hand, qPCR is recommended as a confirmatory diagnosis. LimitationsThe study did not include RCO analysis: a graphical method to evaluate a classification model's performance as both cytology and qPCR are binary (positive/negative) tests rather than continuous quantitative assays, making traditional ROC curve construction less applicable. AcknowledgmentsThe authors highly appreciated the assistance of the College of Veterinary Medicine, University of Basrah, Iraq. Conflict of interestThe authors confirm that there is no conflict of interest in this scientific article. FundingThe College of Veterinary Medicine, University of Basrah, Iraq, was responsible for the financial support provided for this scientific research. Authors' contributionsAll authors have reviewed, discussed, and agreed on their individual contributions before and during the submission of their article. The first author, ALI JARAD, performed sample collection and laboratory analyses as well as organized and prepared research data. Further, gathered and reviewed the scientific literature used in the study. Alsaad K.M., the second author, conducted the statistical analyses. Writing the original draft as well as preparing and writing the full manuscript. Data availabilityAvailable from the corresponding author upon reasonable request. ReferencesAbed, F.A. and Alsaad, K.M. 2017. Clinical, Hematological And Diagnostic Studies of Hemomycoplasma Infection (Mycoplasma ovis) in Sheep of Basrah Governorate. BasJVetRes 16(2), 284–301. Ajaj, E.A., Al-Farwachi, M.I. and Albadrani, B.A. 2025. Molecular detection of Hemotropic mycoplasma in stray dogs in Mosul city. Iraqi J. Vet. Sci. 39(2), 313–317. Al Matwari, E.H., Ahmed, J.A. and Al Saad, K. 2022. Hemomycoplasmosis (Eperythrozoonosis) in domestic animals (a review). IOSR 15(7), 14–19. Arfuso, F., Piccione, G., Guttadauro, A., Monteverde, V., Giudice, E. and Giannetto, C. 2023. Serum C-reactive Protein and Protein Electrophoretic Pattern Correlated with Age in Horses. J. Equine Vet. Sci. 126, 104561. Artika, I.M., Wiyatno, A. and Ma'Roef, C.N. 2020. Pathogenic viruses: molecular detection and characterization. Infect. Genet. Evol. 81, 104215. ArtikaI, I.M., ArtikaYora, M.P., Yora, D.P., Ungke, D. and Jaya, A. 2022. Real-Time Polymerase Chain Reaction Basic Principles and Current Applications. Genes 13, 2387. Atharv, M., Yash, B., Bandal MR Gole., Kadam, A. and Anjum, A. 2023. Elisa: the Immunological Diagnostic Tool. Iarjset 10(11), 1588–2394. Ballados-González, G.G., Cruz-Romero, A., Martínez-Hernández, J.M., Aguilar-Domínguez, M., Vieira, R.F.C., Grostieta, E., Becker, I. and Sánchez-Montes, S. 2025. Confirmation of the presence of Hemotropic Mycoplasma species in working equids from Veracruz, Mexico. Trop. Anim. Health. Prod. 19(575), 225. Bancroft, J.D., Suvarna, K.S. and Layton, C. 2018. (Eds). Bancroft‘s theory and practice of histological techniques E-Book .Elsevier Health Sciences. Beus, K., Goudarztalejerdi, A. and Sazmand, A. 2024. Molecular detection and identification of Hemotropic Mycoplasma species in dogs and their ectoparasites in Iran. Sci. Rep. 5(141), 580. Cray, C., Zaias, J. and Altman, N.H. 2009. Acute Phase Response in Animals: a Review. Comp. Med. 59(6), 517–526. Ciancaglini, E., Fazii, P. and Sforza, G.R. 2005. The use of differential fluorescent staining method to detect bacteriuria. Clin. Lab. 50(11-12), 685–688. Constable, P.D., Hinchcliff, K.W., Done, S.H. and Grunberg, W. 2017. Veterinary Medicine. A textbook of the diseases of cattle, sheep, goats, and horses. 11th ed. USA: WB Saunders Co. De Oliveira Battisti, L., Mongruel, A.C.B., Fagundes-Moreira, R., Baggio-Souza, V., De Souza, V.K.,De Amorim, D.B., Wagner, P.G.C., Souza, U.A.,Gonçalves, A.P., Girotto-Soares, A., De Faria Valle, S., André, M.R. and Soares, J.F. 2024. Postmortemdetection of hemoplasmas (hemotropic Mycoplasma spp.) in South American fur seal (Arctocephalus australis) sampled in Rio Grande do Sul State, southern Brazil. Comparative Immunol. Microbiol. Infect. Dis. 109, 102187. Diab, S.S., Poppenga, R. and Uzal, F.A. 2017. Sudden death in racehorses: postmortem examination protocol. J. Vet. Diag. Invest. 29(4), 442–449. Dieckmann, S.M., Hoelzle, K., Dieckmann, M.P., Straube, I., Hofmann-Lehmann, R. and Hoelzle, L.E. 2012. Occurrence of hemotrophic mycoplasmas in horses with correlation to hematological findings. Vet. Microbiol. 160(1-2), 43–52. Esmaeel, S. and Albadrani, B. 2019. Prevalence and some risk factors of bovine heamotropic mycoplasma in Nineveh province-Iraq. Iraqi J. Vet. Sci. 33(2), 427–431. Jain, S., Gautam, V. and Naseem, S. 2011. Acute-phase proteins: as a diagnostic tool. J. Pharm. Bioallied Sci. 3(1), 118–127. Jarad, A. and Alsaad, K.M. 2016. Clinical, Hematological And Diagnostic Studies Of Mycoplasma Wenyonii Infection In Cattle Of Basrah Governorate Basrah, Iraq. BasJVetRes 15(4), 37–53. Kinoshita, Y., Niwa, H., Uchida-Fujii, E. and Ueno, T. 2024. A real-time PCR assay for the quantification of Mycoplasma equirhinis in tracheal wash samples from Thoroughbred horses. J. Vet. Diagn. Invest. 36(1), 108–111. Korman, R.M., Cerón, J.J., Knowles, T.G., Barker, E.N., Eckersall, P.D. and Tasker, S. 2012. Acute phase response to Mycoplasma haemofelis and ‘Candidatus Mycoplasma haemominutum’ infection in FIV-infected and non-FIV-infected cats. Vet. J. 193(2), 433–438. Leech, N., Barrett, K., Morgan, G.A. 2015. SPSS for intermediate statistics: Use and interpretation: USA: Routledge. 5th ed. Routledge Ligasová, A., Vydržalová, M., Buriánová, R., Brůčková, L., Večeřová, R., Janošťáková, A. and Koberna, K. 2019. A New Sensitive Method for the Detection of Mycoplasmas Using Fluorescence Microscopy. Cells 8(12), 1510. Mandal. 2025. Textbook of veterinary parasitology. Singapore, Springer Nature Singapore Pte Ltd. Martineau, M., Castagnet, S., Kokabi, E., Tricot, A., Jaÿ, M., Léon, A. and Tardy, F. 2023. Detection of Mycoplasma spp. in horses with respiratory disorders. Equine Vet. J. 55(5), 747–754. Martineau, M., Kokabi, E., Taiebi, A., Lefebvre, S., Pradier, S., Jaÿ, M., Tardy, F. and Leon, A. 2023. Epidemiology and pathogenicity of Mycoplasma equirhinis in equine respiratory disorders. Vet. Microbiol. 287, 109926. Messick, J.B. 2004. Hemotrophic mycoplasmas (hemoplasmas): a review and new insights into 167 pathogenic potential. Vet. Clin. Pathol. 33(2), 2. Mouliou, D.S. 2023. C-Reactive Protein: pathophysiology, Diagnosis, False Test Results and a Novel Diagnostic Algorithm for Clinicians. Diseases 1(4), 132. Muszbek, L., Bagoly, Z., Bereczky, Z. and Katona, E. 2008. The involvement of blood coagulation factor XIII in fibrinolysis and thrombosis. Cardiovasc. Hematol. Agents. Med. Chem. 6(3), 190–205. Neimark, H., Johansson, K.E., Rikihisa, Y. and Tully, J.G. 2001. Proposal to transfer to some members of the genera Heamobartonella and Eperythrozoon to the genus Mycoplasma with descriptions of "Candidatus Mycoplasma haemofelis" "Candidatus Mycoplasma haemomuris""Candidatus Mycoplasma haemosuis and "Candidatus Mycoplasma wenyonii". Int. J. Syst. Evol. Microbiol. 51 (Pt 3), 891–899. Novacco, M., Wolf-Jäckel, G., Riond, B. and Hofmann-Lehmann, R. 2012. Humoral immune response to a recombinant hemoplasma antigen in experimental ‘Candidatus Mycoplasma turicensis’ infection. Vet. Microbiol. 157(3-4), 464–470. Saki, C.E. 2009. Clinical Eperythrozoon wenyoni (Adler and Ellenbogan,1934) and Heamobartonella bovis (Donatin) and Lestoquard,1934) infection in a cattle. F. Ü. SagBil. Vet. Derg. 23(2), 117–118. Stockham, S.L and Scott, M.A. 2025. Fundamentals of veterinary clinical pathology, 3rd. Charlotte, NC: Wily. Tasker S. 2022. Hemotropic mycoplasma. Vet. Clin. North Am. Small Anim. Pract. 52(6), 1319–1340. Tasker, S., Hofmann-Lehmann, R., Belák, S., Frymus, T., Addie, D.D., Pennisi, M.G., Boucraut-Baralon, C., Egberink, H., Hartmann, K., Hosie, M.J., Lloret, A., Marsilio, F., Radford, A.D., Thiry, E., Truyen, U. and Möstl, K. 2018. Haemoplasmosis in cats: European guidelines from the ABCD on prevention and management. J. Feline Med. Surg. 20(3), 256–261. Thrall, M.A., Weiser, G., Allison, R.W. and Campbell, T.W. 2012) Veterinary hematology and clinical chemistry. Hoboken, NJ: John Wiley & Sons. Vilhena, H., Tvarijonaviciute, A., Cerón, J., Pastorinho, R., Martinez-Subiela, S., Pastor, J. and Silvestre-Ferreira, A.C. 2018. Acute phase protein response in cats naturally infected by hemotropic mycoplasmas. Comparative Immunol. Microbiol. Infec. Dis. 56, 1–5. Woronzoff-Dashkoff, K.K. 2002. The Wright-Giemsa stain - Secrets revealed. Clin. Lab. Med. 22(1), 15–23. | ||
| How to Cite this Article |
| Pubmed Style Jarad A, Alsaad KM. Evaluation of multiple methods for the diagnosis of equine Hemomycoplasmosis in Misan, Iraq. Open Vet. J.. 2026; 16(2): 861-869. doi:10.5455/OVJ.2026.v16.i2.10 Web Style Jarad A, Alsaad KM. Evaluation of multiple methods for the diagnosis of equine Hemomycoplasmosis in Misan, Iraq. https://www.openveterinaryjournal.com/?mno=288984 [Access: February 27, 2026]. doi:10.5455/OVJ.2026.v16.i2.10 AMA (American Medical Association) Style Jarad A, Alsaad KM. Evaluation of multiple methods for the diagnosis of equine Hemomycoplasmosis in Misan, Iraq. Open Vet. J.. 2026; 16(2): 861-869. doi:10.5455/OVJ.2026.v16.i2.10 Vancouver/ICMJE Style Jarad A, Alsaad KM. Evaluation of multiple methods for the diagnosis of equine Hemomycoplasmosis in Misan, Iraq. Open Vet. J.. (2026), [cited February 27, 2026]; 16(2): 861-869. doi:10.5455/OVJ.2026.v16.i2.10 Harvard Style Jarad, A. & Alsaad, . K. M. (2026) Evaluation of multiple methods for the diagnosis of equine Hemomycoplasmosis in Misan, Iraq. Open Vet. J., 16 (2), 861-869. doi:10.5455/OVJ.2026.v16.i2.10 Turabian Style Jarad, Ali, and Kamal M. Alsaad. 2026. Evaluation of multiple methods for the diagnosis of equine Hemomycoplasmosis in Misan, Iraq. Open Veterinary Journal, 16 (2), 861-869. doi:10.5455/OVJ.2026.v16.i2.10 Chicago Style Jarad, Ali, and Kamal M. Alsaad. "Evaluation of multiple methods for the diagnosis of equine Hemomycoplasmosis in Misan, Iraq." Open Veterinary Journal 16 (2026), 861-869. doi:10.5455/OVJ.2026.v16.i2.10 MLA (The Modern Language Association) Style Jarad, Ali, and Kamal M. Alsaad. "Evaluation of multiple methods for the diagnosis of equine Hemomycoplasmosis in Misan, Iraq." Open Veterinary Journal 16.2 (2026), 861-869. Print. doi:10.5455/OVJ.2026.v16.i2.10 APA (American Psychological Association) Style Jarad, A. & Alsaad, . K. M. (2026) Evaluation of multiple methods for the diagnosis of equine Hemomycoplasmosis in Misan, Iraq. Open Veterinary Journal, 16 (2), 861-869. doi:10.5455/OVJ.2026.v16.i2.10 |